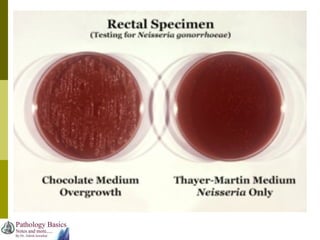

Dr. Ashish Jawarkar discusses the significant health risks of sexually transmitted infections (STIs), particularly their potential complications like infertility and cervical cancer, alongside their asymptomatic nature. Key STIs covered include syphilis, gonorrhoea, and chlamydia, with emphasis on their pathogenicity, diagnosis, and treatment methods. Early screening and joint treatment of partners are crucial for effective management and prevention of further transmission.